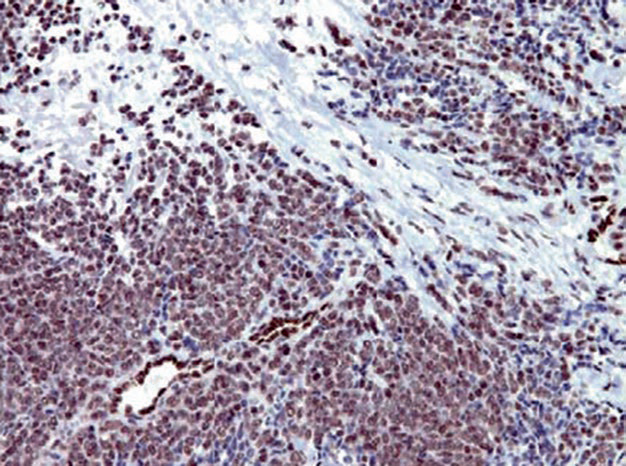
图片

Overview of Immunohistochemistry for Ewing Sarcoma/PNET
First, it needs to be explained that Ewing sarcoma/primitive neuroectodermal tumor (PNET) are both classified as small round cell sarcomas from a morphological perspective. Previously, it was believed that when there was no evidence of primitive neuroepithelial differentiation, it was called Ewing sarcoma; conversely, it was called PNET. However, subsequent studies have found that these two conditions may represent two ends of the same tumor morphological spectrum; the identification of identical cytogenetic abnormalities further supports the correlation between these two types of tumors in terms of histogenesis.
Commonly used immunohistochemical markers for the diagnosis of Ewing sarcoma/PNET include CD99, FLI-1, NKX2.2, DAX-1, CD56, CgA, and Syn.
Table 1. Immunohistochemistry of Ewing Sarcoma/PNET and Related Lesions

(Click to view larger image)
Note:
-
Exhibits a perinuclear staining pattern;
-
Exhibits a nuclear staining pattern.
Detailed Explanation of Some Markers
Positive expression pattern: Cell membrane/cytoplasm
Recommended positive control tissue: PNET
CD99 is a cell surface glycoprotein that plays an important role in T cell adhesion, lymphocyte migration, and extravasation. This protein is expressed on the surface of thymic cortical cells, some mature T lymphocytes, and B lymphocytes, and therefore is expressed in both corresponding normal and neoplastic cells.
CD99 is widely used in the diagnosis of Ewing sarcoma/PNET family tumors, showing cell membrane staining, while some other tumor types may show cytoplasmic staining; in neuroblastoma, CD99 is negative.

Figure 1. Ewing sarcoma, CD99 shows strong positive staining on the cell membrane.
As mentioned above, the expression spectrum of CD99 is relatively broad, resulting in low specificity; therefore, in practical work, tumor diagnosis cannot be made based solely on this marker, especially in cases with similar morphology.
Positive expression pattern: Nucleus
Recommended positive control tissue: Vascular endothelial cells
The FLI-1 gene, also known as transcription factor ERGB, is a member of the ETS proto-oncogene family and is a transcription activator highly expressed during embryonic development. This gene is one of the genes involved in the t(11;22)(q24;q12) translocation, which is the most common and specific molecular genetic abnormality in Ewing sarcoma/PNET family tumors, seen in over 90% of cases. Antibodies targeting the FLI-1 gene product are also highly specific for this group of tumors.
Figure 2. Ewing sarcoma, FLI-1 shows strong positive expression in the nucleus; note that the vascular endothelial cells in the image can serve as an internal control.
It should be noted that FLI-1 expression is not limited to PNET family tumors; for example, this marker is also a good marker for vascular tumors, and some malignant melanomas (mainly aggressive subtypes) can also express it. One pitfall in the application of FLI-1 is that blasts in acute lymphoblastic leukemia express this marker, and since CD99 is also positive and the morphology resembles PNET, misdiagnosis is easy. In such cases, adding TdT is crucial for definitive diagnosis.
NKX2.2 is a member of the NK family of transcription factors, involved in the differentiation of the ventral region of the central nervous system, pancreatic islet cells, and gastrointestinal endocrine cells. Molecular studies have confirmed that NKX2.2 is a mediator of the specific EWS/FLI-1 translocation in Ewing sarcoma; over 80% of Ewing sarcoma/PNET family tumors express NKX2.2. Normally, NKX2.2 is also expressed in pancreatic islet cells, small intestinal endocrine cells, and tumors derived from these cells.
DAX-1 is a nuclear receptor protein, a member of the orphan nuclear receptor family, encoded by the NR0B1 gene, regulating steroid hormone synthesis. Therefore, this marker is used as a related marker for adrenal cortical tumors. However, in the presence of the EWS/FLI-1 translocation, subsequent genetic changes lead to the expression of DAX-1, so Ewing sarcoma with this translocation also exhibits overexpression of DAX-1.
CD56, also known as neural cell adhesion molecule, functions as a mediator in cell-cell adhesion, cell-matrix interactions, and is involved in regulating processes such as cell adhesion, synaptic plasticity, cell migration, proliferation, differentiation, and apoptosis. CD56 is an important molecule in nervous system development and differentiation, normally expressed in neuroectodermal cells, glial cells, myoblasts, skeletal muscle, neuromuscular junctions, and tumors derived from these cells. Additionally, this marker is expressed in NK cells and activated T cells, playing an important role in immune responses. In summary, in practical pathological diagnosis, CD56 can be used as a marker for neurogenic tumors, neuroendocrine tumors, and NK cell tumors.

Figure 3. In olfactory neuroblastoma, CD56 shows cell membrane staining.
MaiMai Recommendation: “Precise diagnosis starts with choosing a high-performance immunohistochemical diagnostic antibody. This issue, MaiMai recommends the following products to help you diagnose with ease!”
|
Antibody Name
|
Clone Number
|
Positive Control
|
Cellular Localization
|
|
CD56*
|
MX039
|
Non-small cell carcinoma, appendix
|
Cell membrane
|
|
CD99
|
O13
|
Primitive neuroectodermal tumor, tonsil
|
Cell membrane/cytoplasm
|
|
CgA*
|
MX018
|
Pheochromocytoma, neuroendocrine carcinoma
|
Cytoplasm
|
|
NKX2.2
|
EP336
|
Pancreas, neuroendocrine carcinoma
|
Membrane/nucleus
|
*Marked as MaiXin clone products
For more information, please contact: 800-8581156 or 400-889-9853